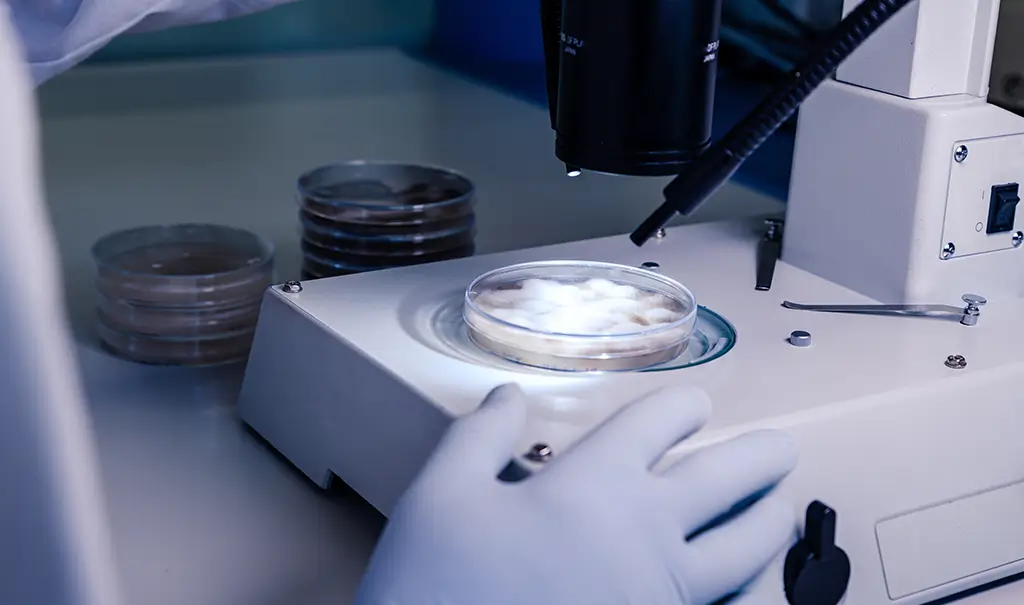

Edit Content
Aman Hospital is a luxurious healthcare facility established in Doha, Qatar, and owned by Jaidah Holdings.
This new 100+ bed hospital will define the future of healthcare delivery in Qatar and the region by combining unparalleled professional expertise, cutting-edge technology, state-of-the-art equipment, service excellence, a relentless pursuit of medical innovation, and deluxe hospitality, all with a focus on patient-centered care.
Contact Info
-
F Ring Rd, Doha, Qatar
Zone 47, Building 412
PO Box: 8199 - +974 4400 4400
- [email protected]